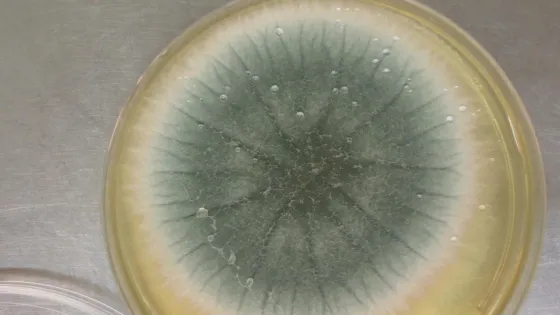
1776697773030586_07oeeT61-v1

- Ученые обнаружили споры двух видов грибков на сборочных площадках NASA, способных пережить космическую радиацию и низкие температуры.
- Это открытие указывает на необходимость более тщательной защиты Марса от земной жизни.
- Данные микробы могут помочь оценить риск выживания земных микробов в путешествии к Марсу.
- Информация поможет NASA разработать стратегии защиты других планет и организации миссий.
- Исследование проводилось на аналогах обшивки марсохода, космического корабля и марсианского грунта.
- Споры грибков Aspergillus calidoustus и Aspergillus fumigatus выживали в условиях, аналогичных марсианским.
- Споры грибков превзошли бактерии Bacillus pumilus в выживаемости при высоком уровне радиации и низких температурах.
- Данные результаты должны учитываться при сборке и обработке новых марсианских миссий.
Выявлены два вида грибков, способных пережить путешествие с Земли на Марс
20 апр 2026
Краткий пересказ
от нейросети YandexGPT
Источник:
tass.ru
Обложка: Изображение из статьи. Грибок Aspergillus fumigatus © Jankaan/ Wikimedia Commons/ CC BY-SA 3.0